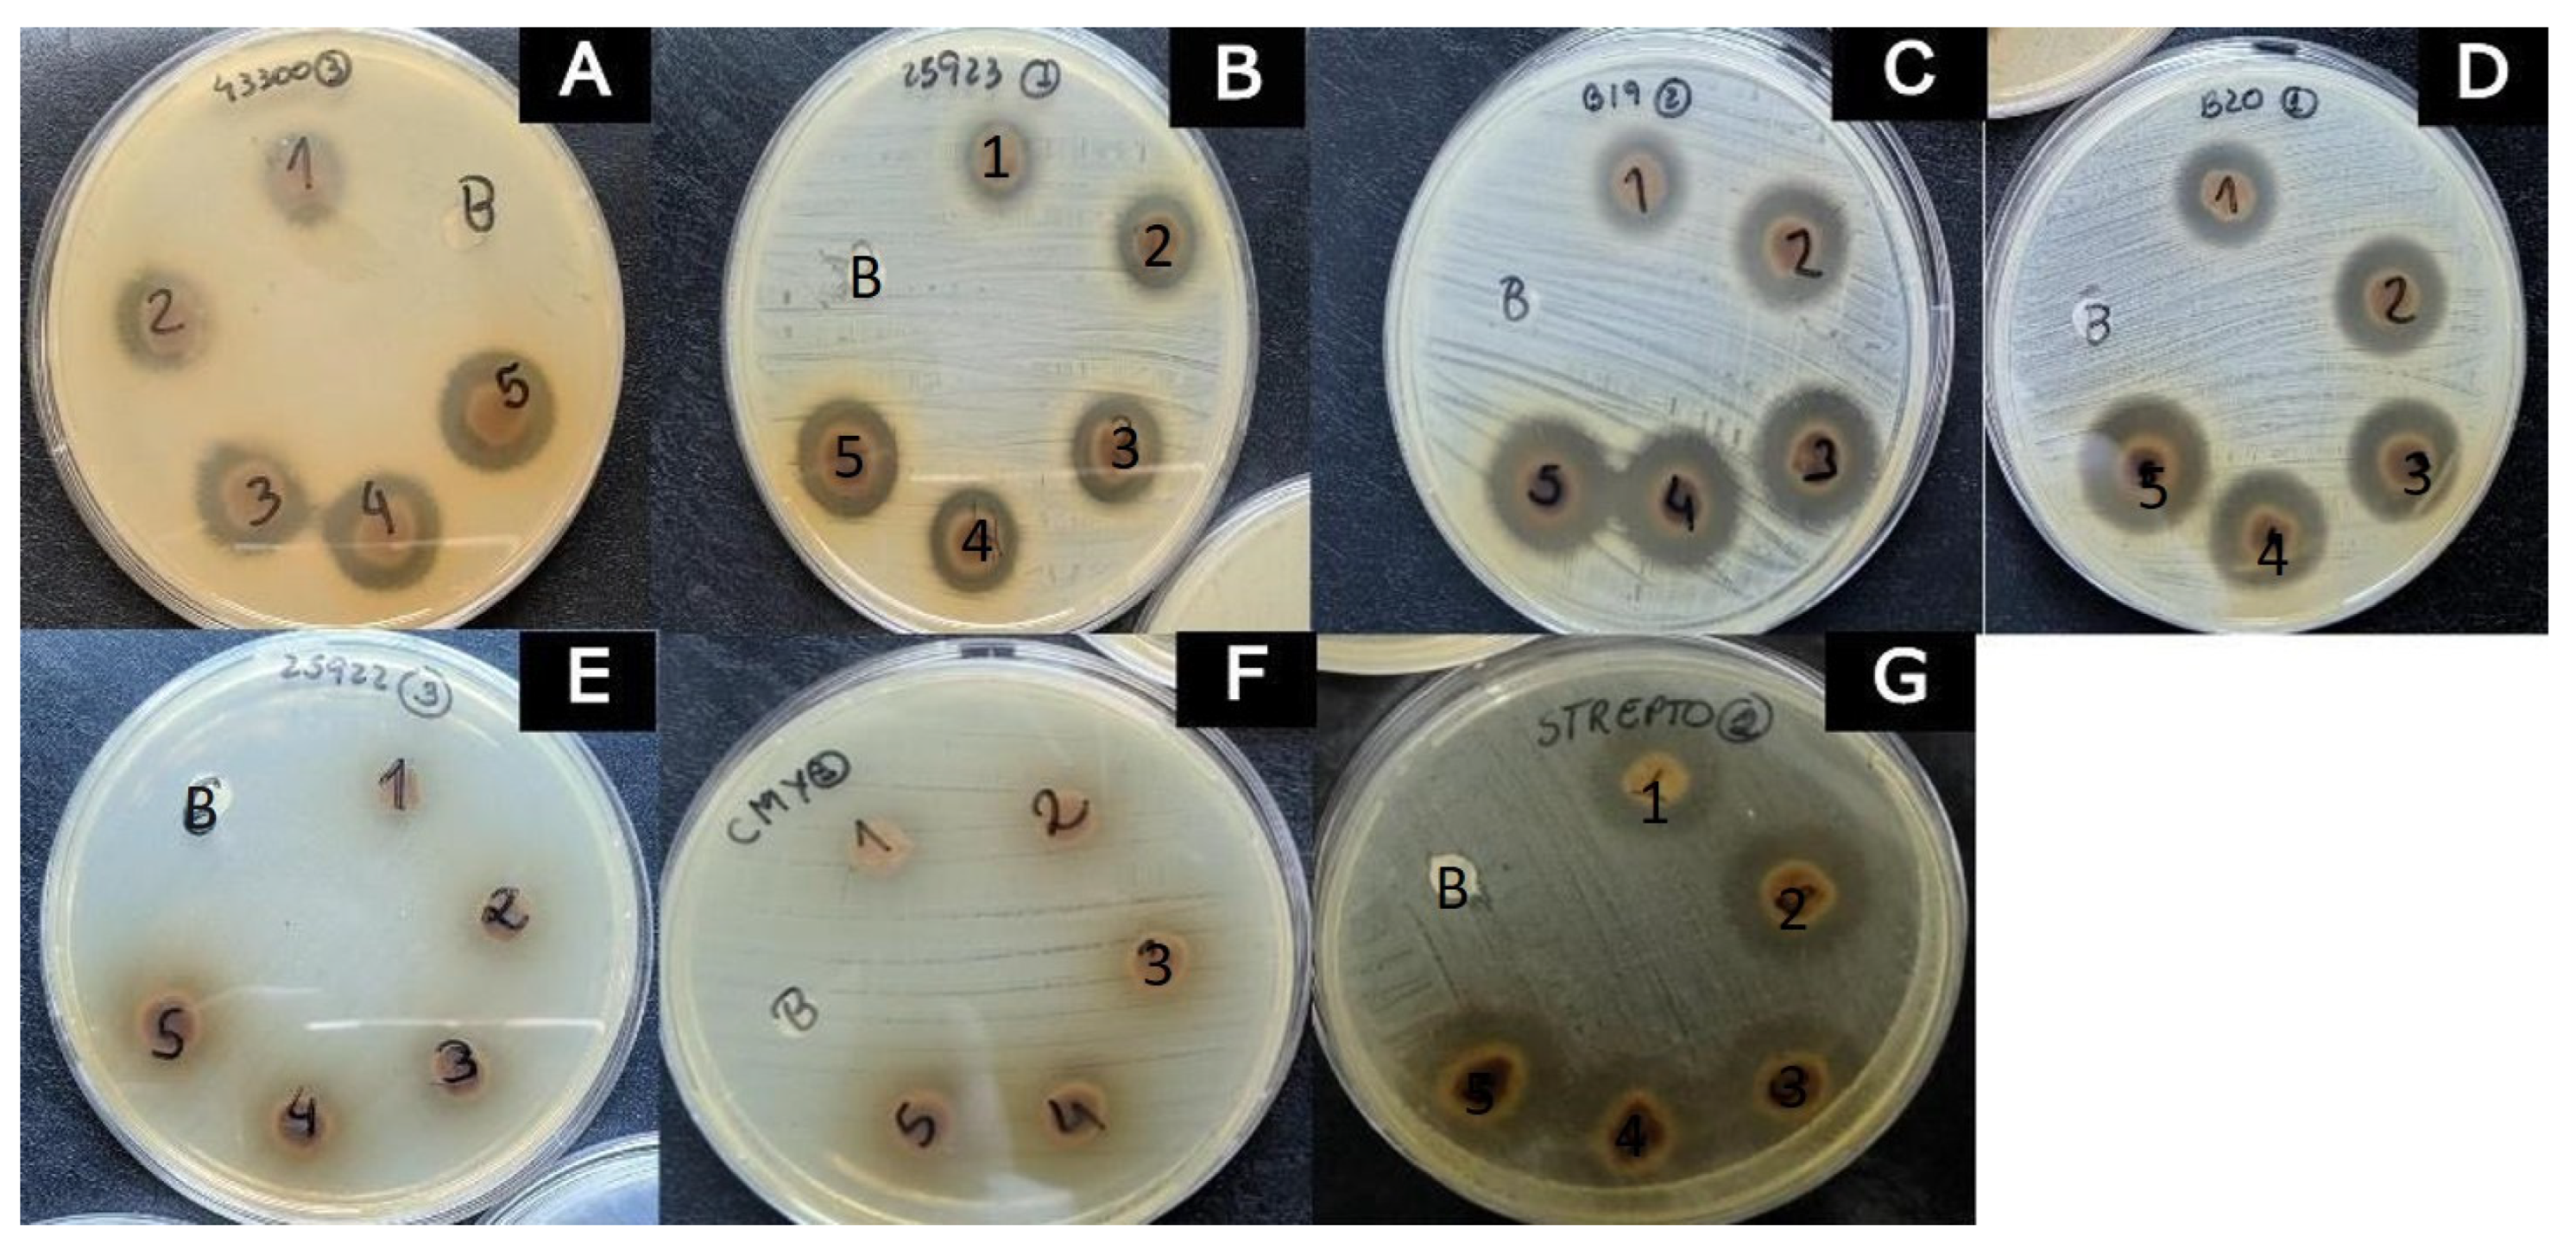
Microorganisms 11 01784 g002 Microorganisms 11 01784 g002
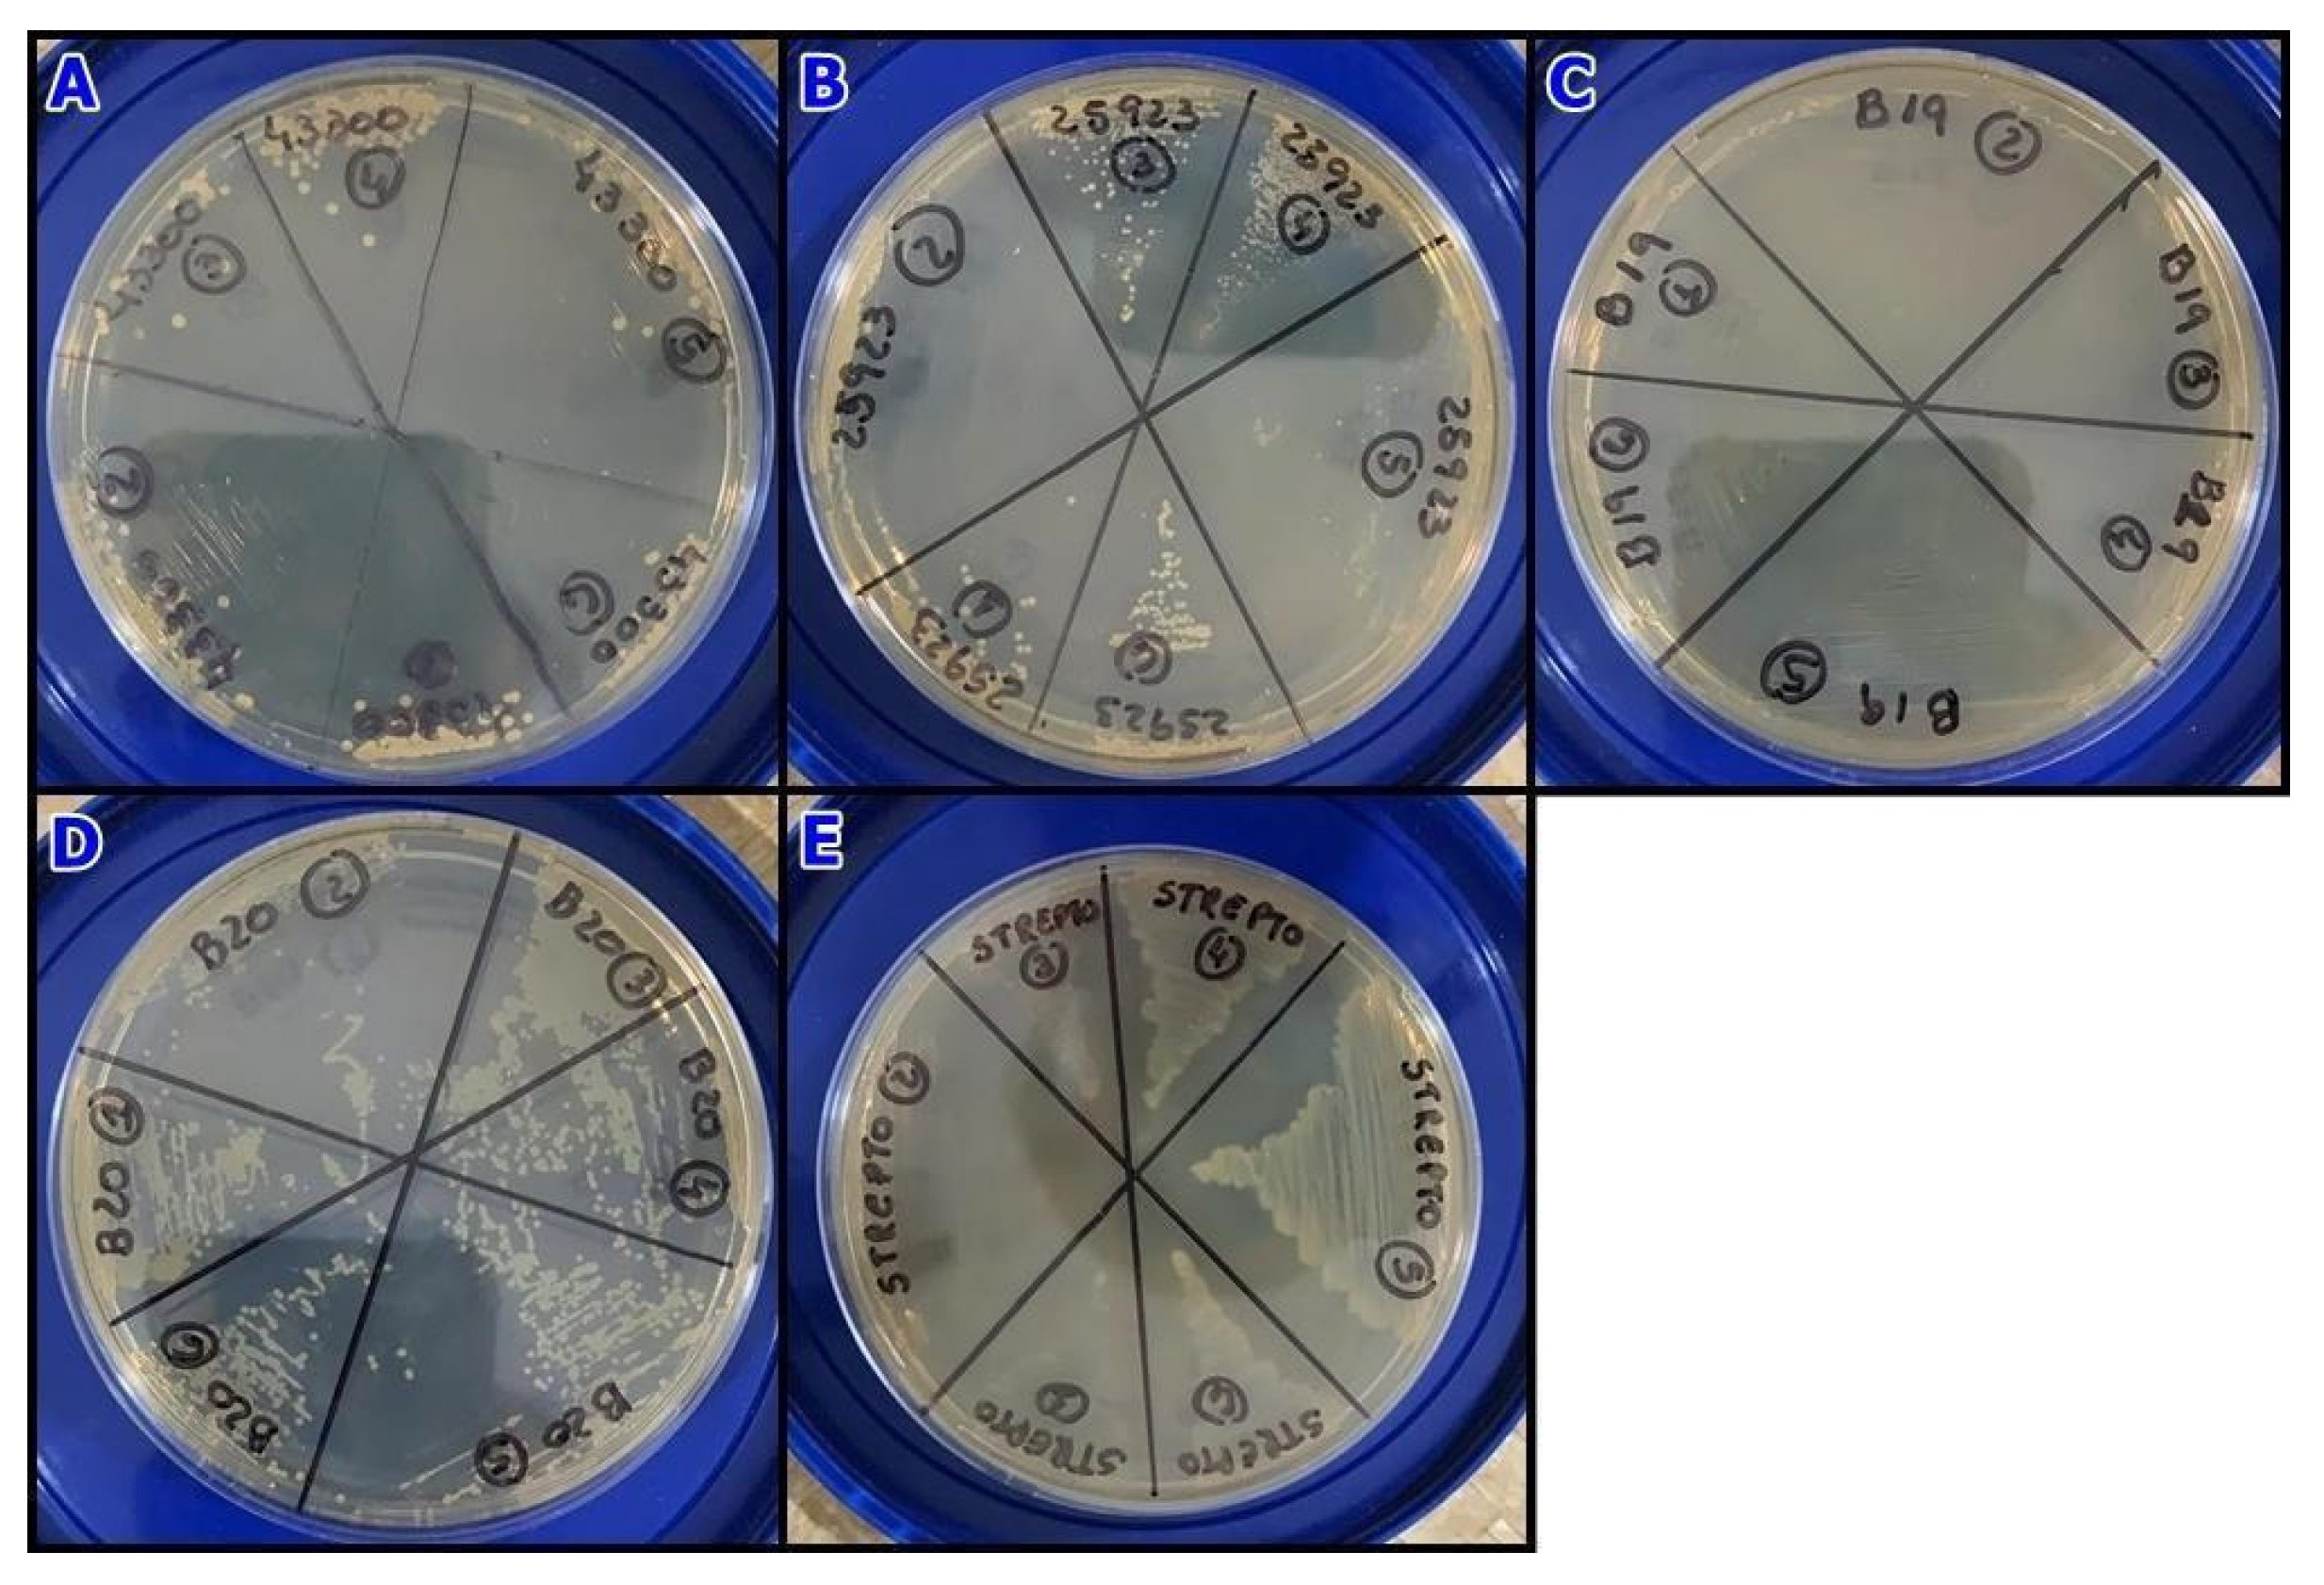
Microorganisms 11 01784 g004 Microorganisms 11 01784 g004

Antimicrobial Activity of Psidium guajava Aqueous Extract against Sensitive and Resistant Bacterial Strains
Abstract
1. Introduction
2. Materials and Methods
2.1. Chemicals and Reagents
2.2. Plant Material, Extraction, and High Performance Liquid Chromatography
2.3. Total Phenolic and Tannin Content
2.4. Antioxidant Activity
2.5. Antimicrobial Activity of the Extract
2.5.1. Disk Diffusion Test
2.5.2. Broth Microdilution Test
2.5.3. Minimum Bactericidal Concentration Determination
2.6. Statistical Analysis
3. Results and Discussion
3.1. Chemical Analysis of Plant Extract
3.2. Antimicrobial Extract Evaluation
4. Conclusions
Author Contributions
Funding
Conflicts of Interest
References
- Hughes, D.; Andersson, D.I. Evolutionary trajectories to antibiotic resistance. Annu. Rev. Microbiol. 2017, 71, 579–596. [Google Scholar] [CrossRef] [PubMed]
- Talebi Bezmin Abadi, A.; Rizvanov, A.A.; Haertlé, T.; Blatt, N.L. World Health Organization Report: Current Crisis of Antibiotic Resistance. BioNanoScience 2019, 9, 778–788. [Google Scholar] [CrossRef]
- World Health Organization (Internet). WHO Publishes List of Bacteria for Which New Antibiotics Are Urgently Needed. Available online: https://www.who.int/news/item/27-02-2017-who-publishes-list-of-bacteria-for-which-new-antibiotics-are-urgently-needed (accessed on 3 March 2023).
- Rossiter, S.E.; Fletcher, M.H.; Wuest, W.M. Natural products as platforms to overcome antibiotic resistance. Chem. Rev. 2017, 1179, 12415–12474. [Google Scholar] [CrossRef] [PubMed]
- Adamczak, A.; Ożarowski, M.; Karpiński, T.M. Antibacterial activity of some flavonoids and organic acids widely distributed in plants. J. Clin. Med. 2019, 9, 109. [Google Scholar] [CrossRef]
- Daswani, P.G.; Gholkar, M.S.; Birdi, T.J. Psidium guajava: A single plant for multiple health problems of rural Indian population. Pharmacogn. Rev. 2017, 11, 167–174. [Google Scholar] [CrossRef]
- Huang, J.; Li, C.; Ma, J.; Xu, K.; Chen, X.; Jiang, J.; Zhang, D. Chemical constituents of Psidium guajava leaves and their antibacterial activity. Phytochemistry 2021, 186, 112746. [Google Scholar] [CrossRef]
- Ryu, B.; Cho, H.M.; Zhang, M.; Lee, B.W.; Doan, T.P.; Park, E.J.; Lee, H.J.; Oh, W.K. Meroterpenoids from the leaves of Psidium guajava (guava) cultivated in Korea using MS/MS-based molecular networking. Phytochemistry 2021, 186, 112723. [Google Scholar] [CrossRef]
- Biswas, B.; Rogers, K.; McLaughlin, F.; Daniels, D.; Yadav, A. Antimicrobial activities of leaf extracts of guava (Psidium guajava L.) on two Gram-negative and Gram-positive bacteria. Int. J. Microbiol. 2013, 2013, 746165. [Google Scholar] [CrossRef]
- Dhiman, A.; Nanda, A.; Ahmad, S.; Narasimhan, B. In vitro antimicrobial activity of methanolic leaf extract of Psidium guajava L. J. Pharm. Bioallied. Sci. 2011, 3, 226, 2011. [Google Scholar] [CrossRef]
- Jaiarj, P.; Khoohaswan, P.; Wongkrajang, Y.; Peungvicha, P.; Suriyawong, P.; Saraya, M.L.S.; Ruangsomboon, O. Anticough and antimicrobial activities of Psidium guajava Linn. leaf extract. J. Ethnopharmacol. 1999, 67, 203–212. [Google Scholar] [CrossRef]
- Kidaha, M.L.; Alakonya, A.E.; Nyende, A.B. Bioactivity determination of methanol and water extracts for roots and leaves of Kenyan Psidium guajava L. landraces against pathogenic bacteria. SpringerPlus 2013, 2, 670. [Google Scholar] [CrossRef] [PubMed]
- Ratnakaran, P.; Barve, A.A.; Patnekar, K.A.; Patil, N.C.; Udmale, N.M.; Ramchandran, S.; Durve-Gupta, A. Phytochemical and antimicrobial activities of leaf extract of Guava (Psidium guajava L.). Int. J. Appl. Res. 2020, 6, 106–110. [Google Scholar]
- Nair, R.; Chanda, S. In-vitro antimicrobial activity of Psidium guajava L. leaf extracts against clinically important pathogenic microbial strains. Braz. J. Microbiol. 2007, 38, 452–458. [Google Scholar] [CrossRef]
- Rattanachaikunsopon, P.; Phumkhachorn, P. Contents and antibacterial activity of flavonoids extracted from leaves of Psidium guajava. J. Med. Plants Res. 2010, 4, 393–396. [Google Scholar]
- Raj, A.; Menon, V.; Sharma, N. Phytochemical screening, antimicrobial, antioxidant and cytotoxic potential of different extracts of Psidium guajava leaves. Vegetos 2020, 33, 750–758. [Google Scholar] [CrossRef]
- Bolzan, T.C.A.; Severi, J.A.; Villanova, J.C.O.; Donatele, D.M.; Madureira, A.P.; Marcos, S.Z. Prospecção de extratos vegetais como coadjuvantes de higiene bucal em cães raça Labrador Retriever. Pubvet 2020, 14, 1–8. [Google Scholar] [CrossRef]
- Chakraborty, S.; Afaq, N.; Singh, N.; Majumdar, S. Antimicrobial activity of Cannabis sativa, Thuja orientalis and Psidium guajava leaf extracts against methicillin-resistant Staphylococcus aureus. J. Integr. Med. 2018, 16, 350–357. [Google Scholar] [CrossRef]
- Shetty, S.; Shetty, R.M.; Rahman, B.; Reddy, M.S.; Shetty, S.R.; Vannala, V.; Desai, V.; Halkai, R. Comparison of time-kill assay to evaluate the antimicrobial efficacy of garlic (Allium sativum) and guava (Psidium guajava) extracts on periodontal pathogens. Contemp. Clin. Dent. 2021, 12, 389–395. [Google Scholar] [CrossRef]
- Sanches, N.R.; Cortez, D.A.G.; Schiavini, M.S.; Nakamura, C.V.; Filho, B.P.D. An evaluation of antibacterial activities of Psidium guajava (L.). Braz. Arch. Biol. Technol. 2005, 48, 429–436. [Google Scholar] [CrossRef]
- Millones-Gómez, P.A.; Maurtua-Torres, D.; Bacilio-Amaranto, R.; Calla-Poma, R.D.; Requena-Mendizabal, M.F.; Valderrama-Negron, A.C.; Calderon-Miranda, M.A.; Calla-Poma, R.A.; Leuyacc, M.E.H. Antimicrobial activity and antiadherent effect of Peruvian Psidium guajava (Guava) leaves on a cariogenic biofilm model. J. Contemp. Dent. Pract. 2020, 21, 733–740. [Google Scholar]
- Patel, P.; Joshi, C.; Birdi, T.; Kothari, V. Anti-infective efficacy of Psidium guajava L. leaves against certain pathogenic bacteria. F1000Research 2019, 8, 12. [Google Scholar] [CrossRef] [PubMed]
- Shafiei, Z.; Rahim, Z.H.A.; Philip, K.; Thurairajah, N. Antibacterial and anti-adherence effects of a plant extract mixture (PEM) and its individual constituent extracts (Psidium sp., Mangifera sp., and Mentha sp.) on single-and dual-species biofilms. PeerJ 2016, 4, e2519. [Google Scholar] [CrossRef]
- Iha, S.M.; Migliato, K.F.; Vellosa, J.C.R.; Sacramento, L.V.S.; Pietro, R.C.L.; Isaac, V.L.B.; Brunetti, I.L.; Corrêa, M.A.; Salgado, H.R.N. Phytochemical study of guava (Psidium guajava L.) with potential antioxidant activity aiming at developing a phytocosmetic formulation. Rev. Bras. Farmacogn. 2008, 18, 387–393. [Google Scholar] [CrossRef]
- Epifanio, N.M.M.; Cavalcanti, L.R.I.; Santos, K.F.D.; Duarte, P.S.C.; Kachlicki, P.; Ożarowski, M.; Riger, C.J.; Chaves, D.S.A. Chemical characterization and in vivo antioxidant activity of parsley (Petroselinum crispum) aqueous extract. Food Funct. 2020, 11, 5346–5356. [Google Scholar] [CrossRef]
- Quettier-Deleu, C.; Gressier, B.; Vasseur, J.; Dine, T.; Brunet, C.; Luyckx, M.; Cazin, M.; Cazin, J.C.; Bailleul, F.; Trotin, F. Phenolic compounds and antioxidant activities of buckwheat (Fagopyrum esculentum Moench) hulls and flour. J. Ethnopharmacol. 2000, 72, 35–42. [Google Scholar] [CrossRef]
- Rufino, M.S.M.; Alves, R.E.; Brito, E.S.; Morais, S.M.; Sampaio, C.G.; Pérez-Jiménez, J.; Saura-Calixto, F.D. Metodologia científica: Determinação da Atividade Antioxidante Total em Frutas Pela Captura do Radical Livre ABTS+. Embrapa Agroindústria Tropical. Comunicado técnico 2007. Available online: https://ainfo.cnptia.embrapa.br/digital/bitstream/CNPAT/10225/1/Cot_128.pdf (accessed on 1 February 2023).
- CLSI. Performance Standards for Antimicrobial Susceptibility Testing, 30th ed.; CLSI Supplement M100; Clinical and Laboratory Standards Institute: Wayne, PA, USA, 2020. [Google Scholar]
- Rakmai, J.; Cheirsilp, B.; Mejuto, J.C.; Simal-Gándara, J.; Torrado-Agrasar, A. Antioxidant and antimicrobial properties of encapsulated guava leaf oil inhydroxypropyl-beta-cyclodextrin. Ind. Crops Prod. 2018, 111, 219–225. [Google Scholar] [CrossRef]
- Nantitanon, W.; Yotsawimonwat, S.; Okonogi, S. Factors influencing antioxidant activities and total phenolic content of guava leaf extract. LWT-Food Sci. Technol. 2010, 43, 1095–1103. [Google Scholar] [CrossRef]
- Haida, K.S.; Baron, Â.; Haida, K.S.; Faci, D.D.; Haas, J.; da Silva, F.J. Compostos fenólicos totais e atividade antioxidante de duas variedades de goiaba e arruda phenolic compounds and antioxidant activity of two varieties of guava and rue. Rev. De Atenção À Saúde 2011, 9, 11–19. [Google Scholar]
- Camarena-Tello, J.C.; Martínez-Flores, H.E.; Garnica-Romo, M.G.; Padilla-Ramírez, J.S.; Saavedra-Molina, A.; Alvarez-Cortes, O.; Bartolomé-Camacho, M.C.; Rodiles-López, J.O. Quantification of phenolic compounds and in vitro radical scavenging abilities with leaf extracts from two varieties of Psidium guajava L. Antioxidants 2018, 7, 34. [Google Scholar] [CrossRef]
- de Araújo, A.A.; Soares, L.A.L.; Ferreira, M.R.A.; de Souza Neto, M.A.; da Silva, G.R.; de Araújo, R.F., Jr.; Guerra, G.C.B.; de Melo, M.C.N. Quantification of polyphenols and evaluation of antimicrobial, analgesic and anti-inflammatory activities of aqueous and acetone–water extracts of Libidibia ferrea, Parapiptadenia rigida and Psidium guajava. J. Ethnopharmacol. 2014, 156, 88–96. [Google Scholar] [CrossRef]
- Sehgal, S.; Khanna, P.; Yadav, R. Phytochemical constituents of Hibiscus rosa-sinensis, Laurus nobilis and Psidium guajava Leaves and their antimicrobial Activity. Ind. J. Nat. Sci. 2020, 11, 28549–28557. [Google Scholar]
- Metwally, A.M.; Omar, A.A.; Harraz, F.M.; El Sohafy, S.M. Phytochemical investigation and antimicrobial activity of Psidium guajava L. leaves. Pharmacogn. Mag. 2010, 6, 212–218. [Google Scholar] [CrossRef] [PubMed]
- Moorthy, K.; Punitha, T.; Vinodhini, R.; Sureshkumar, B.T.; Vijayalakshmi, P.; Thajuddin, N. Antimicrobial activity and qualitative phytochemical analysis of Punica granatum Linn. (PERICARP). J. Med. Plants Res. 2013, 7, 474–479. [Google Scholar]
- Ekor, M. The growing use of herbal medicines: Issues relating to adverse reactions and challenges in monitor-ing safety. Front. Pharmacol. 2014, 4, 177. [Google Scholar] [CrossRef]
- Venegas, G.; Gómez-Mora, J.A.; Meraz-Rodríguez, M.A.; Flores-Sánchez, M.A.; Ortiz-Miranda, L.F. Effect of flavonoids on anti-microbial activity of microorganisms present in dental plaque. Heliyon 2019, 13, e03013. [Google Scholar] [CrossRef] [PubMed]
- Amin, M.U.; Khurram, M.; Khattak, B.; Khan, J. Antibiotic additive and synergistic action of rutin, morin and quercetin against methicillin resistant Staphylococcus aureus. BMC Complement. Altern. Med. 2015, 12, 59. [Google Scholar] [CrossRef]
- Gelatti, L.C.; Bonamigo, R.R.; Becker, A.P.; d’Azevedo, P.A. Staphylococcus aureus resistentes à meticilina: Disseminação emergente na comunidade. An. Bras. Dermatol. 2009, 84, 501–506. [Google Scholar] [CrossRef]
- Donkor, E.S.; Kotey, F.C.N. Methicillin-resistant Staphylococcus aureus in the oral cavity: Implications for antibiotic prophylaxis and surveillance. Infect. Dis. Res. Treat. 2020, 13, 1–8. [Google Scholar] [CrossRef]
- Jaradat, Z.W.; Ababneh, Q.O.; Shaaban, S.T.; Alkofahi, A.A.; Assaleh, D.; Shara, A.A. Methicillin resistant Staphylococcus aureus and public fomites: A review. Pathog. Glob. Health 2020, 114, 426–450. [Google Scholar] [CrossRef]
- Turner, N.A.; Sharma-Kuinkel, B.K.; Maskarinec, S.A.; Eichenberger, E.M.; Shah, P.P.; Carugati, M.; Holland, T.L.; Fowler, V.G. Methicillin-resistant Staphylococcus aureus: An overview of basic and clinical research. Nat. Rev. Microbiol. 2019, 17, 203–218. [Google Scholar] [CrossRef]

| Strains | Code | Resistance Pattern |
|---|---|---|
| E. coli (ESBL) | CMY-2 | Betalactamic resistance (Penicillins and cephalosporins up to third generation) |
| E.coli | ATCC 25922 | Wild-type E. coli |
| S. aureus (MRSA) | ATCC 43300 | Methicillin resistant |
| S.aureus | ATCC 23923 | Wild-Type S. aureus |
| S.pseudintermedius | B19 | Resistant to Sulfametoxazole + trimetoprim |
| S.pseudintermedius | B20 | No expressed resistance to any tested antimicrobials |
| Streptococcus spp. beta-hemolytic | - | No expressed resistance to any tested antimicrobials |
| Peak | Retention Time (Rt) | Concentration (%) | λmax (nm) | Name |
|---|---|---|---|---|
| 1 | 9.711 | 1.079 | 278 | Tannic acid |
| 2 | 15.068 | 3.699 | 270 | Gallic acid |
| 3 | 17.838 | 1.316 | 242, 294 | Protocatechuic acid |
| 4 | 18.865 | 16.549 | 257, 358 | Rutin |
| 5 | 19.579 | 14.131 | 270, 323 | Hesperidin |
| 6 | 23.807 | 19.305 | 258, 378 | Quercetin |
| 7 | 24.243 | 13.965 | 240, 280 | Cinnamic derivative |
| 8 | 24.794 | 0.444 | - | n.i. |
| 9 | 25.785 | 0.836 | 267 | Syringic acid |
| 10 | 27.481 | 10.071 | 235, 322 | Cinnamic derivative |
| 11 | 28.071 | 5.553 | 252, 352, 369 | Ellagic acid |
| 12 | 28.517 | 7.221 | 220, 329 | Rosmarinic acid |
| Concentration (mg/mL) | 2.3 | 4.6 | 6.8 | 9.1 | 11.4 |
|---|---|---|---|---|---|
| Staphylococcus aureus (resistant) | 14.0 ± 2.00 a | 15.3 ± 2.31 a | 16.7 ± 1.15 a | 17.3 ± 2.31 a | 18.0 ± 3.46 a |
| Staphylococcus aureus (wild-type) | 9.3 ± 1.15 a | 11.3 ± 1.15 a | 14.0 ± 0.00 b | 14.7 ± 1.15 b | 16.0 ± 0.00 b |
| Staphylococcus pseudintermedius (resistant) | 13.3 ± 1.15 a | 15.3 ± 1.15 b | 15.3 ± 1.15 b | 16.0 ± 0.00 b | 18.0 ± 0.00 b |
| Staphylococcus pseudintermedius (wild-type) | 13.3 ± 1.15 a | 15.3 ± 1.15 b | 15.3 ± 1.15 b | 16.0 ± 0.00 b | 18.0 ± 0.00 c |
| Streptococcus beta-hemolytic (wild-type) | 14.7 ± 1.15 a | 18.7 ± 1.53 a | 18.0 ± 4.0 a | 19.3 ± 3.06 a | 21.0 ± 2.0 a |
Disclaimer/Publisher’s Note: The statements, opinions and data contained in all publications are solely those of the individual author(s) and contributor(s) and not of MDPI and/or the editor(s). MDPI and/or the editor(s) disclaim responsibility for any injury to people or property resulting from any ideas, methods, instructions or products referred to in the content. |
© 2023 by the authors. Licensee MDPI, Basel, Switzerland. This article is an open access article distributed under the terms and conditions of the Creative Commons Attribution (CC BY) license (https://creativecommons.org/licenses/by/4.0/).
Share and Cite
Pereira, G.A.; Chaves, D.S.d.A.; Silva, T.M.e.; Motta, R.E.d.A.; Silva, A.B.R.d.; Patricio, T.C.d.C.; Fernandes, A.J.B.; Coelho, S.d.M.d.O.; Ożarowski, M.; Cid, Y.P.; et al. Antimicrobial Activity of Psidium guajava Aqueous Extract against Sensitive and Resistant Bacterial Strains. Microorganisms 2023, 11, 1784. https://doi.org/10.3390/microorganisms11071784
Pereira GA, Chaves DSdA, Silva TMe, Motta REdA, Silva ABRd, Patricio TCdC, Fernandes AJB, Coelho SdMdO, Ożarowski M, Cid YP, et al. Antimicrobial Activity of Psidium guajava Aqueous Extract against Sensitive and Resistant Bacterial Strains. Microorganisms. 2023; 11(7):1784. https://doi.org/10.3390/microorganisms11071784
Chicago/Turabian StylePereira, Geraldo Augusto, Douglas Siqueira de Almeida Chaves, Taynara Monsores e Silva, Raissa Emidio de Araújo Motta, Adriana Barbosa Rocha da Silva, Thereza Cristina da Costa Patricio, Anna Julia Bessa Fernandes, Shana de Mattos de Oliveira Coelho, Marcin Ożarowski, Yara Peluso Cid, and et al. 2023. "Antimicrobial Activity of Psidium guajava Aqueous Extract against Sensitive and Resistant Bacterial Strains" Microorganisms 11, no. 7: 1784. https://doi.org/10.3390/microorganisms11071784
APA StylePereira, G. A., Chaves, D. S. d. A., Silva, T. M. e., Motta, R. E. d. A., Silva, A. B. R. d., Patricio, T. C. d. C., Fernandes, A. J. B., Coelho, S. d. M. d. O., Ożarowski, M., Cid, Y. P., & Karpiński, T. M. (2023). Antimicrobial Activity of Psidium guajava Aqueous Extract against Sensitive and Resistant Bacterial Strains. Microorganisms, 11(7), 1784. https://doi.org/10.3390/microorganisms11071784

